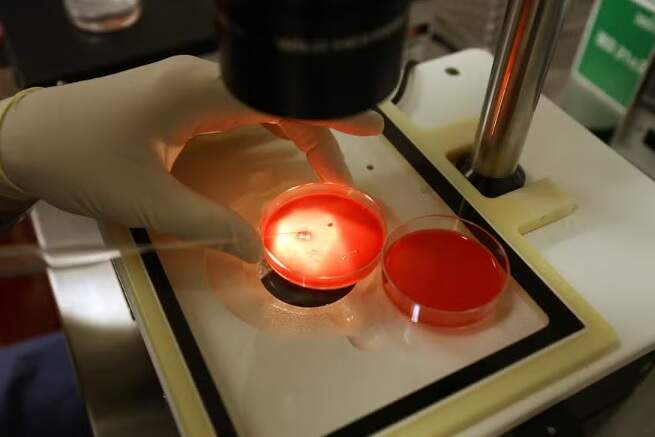

Quinta-feira, 02 de Julho de 2026
Quinta-feira, 02 de Julho de 2026
Por Redação Rádio Pampa | 22 de fevereiro de 2024
Uma decisão da Suprema Corte do Alabama que considera embriões congelados em tubos de ensaio como crianças chocou o mundo da medicina reprodutiva, lançando dúvidas sobre o cuidado com a fertilidade para futuros pais e levantando questões legais complexas com implicações que vão muito além do Estado.
Na última terça-feira (20), Karine Jean-Pierre, secretária de imprensa da Casa Branca, disse que a decisão causaria “exatamente o tipo de caos que esperávamos quando a Suprema Corte revogou a Roe vs. Wade [que garantia o direito constitucional ao aborto] e abriu caminho para políticos ditarem algumas das decisões mais pessoais que as famílias podem tomar.”
Falando com repórteres a bordo do Air Force One enquanto o presidente Joe Biden viajava para a Califórnia, Jean-Pierre reiterou o apelo da administração Biden para que o Congresso codifique as proteções de Roe vs. Wade em lei federal.
“Como lembrete, este é o mesmo estado cujo procurador-geral ameaçou processar pessoas que ajudam mulheres a viajar para fora do estado em busca do cuidado de que precisam”, disse ela, referindo-se ao Alabama, que começou a aplicar uma proibição total do aborto em junho de 2022.
Os juízes emitiram a decisão em casos de apelação movidos por casais cujos embriões foram destruídos em 2020, quando um paciente do hospital retirou embriões congelados de tanques de nitrogênio líquido e os deixou cair no chão.
Referindo-se à linguagem antiaborto na Constituição estadual, a opinião majoritária dos juízes disse que uma lei de 1872 que permite aos pais processar por morte injusta de uma criança se aplica a “crianças não-nascidas”, sem exceção para “crianças extrauterinas”.
“Mesmo antes do nascimento, todos os seres humanos têm a imagem de Deus, e suas vidas não podem ser destruídas sem apagar sua glória”, escreveu o chefe de Justiça Tom Parker em uma opinião concordante.
Riscos
Especialistas em infertilidade e especialistas legais disseram que a decisão teve efeitos potencialmente profundos, que devem preocupar todos os americanos que possam precisar acessar serviços reprodutivos como a fertilização in vitro.
Uma em cada seis famílias lida com infertilidade, de acordo com Barbara Collura, presidente e diretora executiva da Resolve, que representa os interesses de pacientes com infertilidade.
“Você mudou o status de um grupo microscópico de células para agora ser uma pessoa ou uma criança”, disse Collura. “Eles não disseram que a fertilização in vitro é ilegal, e eles não disseram que você não pode congelar embriões. É ainda pior, não há um plano de ação.”
Tornou-se protocolo médico padrão durante a fertilização in vitro extrair o máximo de óvulos possível de uma mulher, depois fertilizá-los para criar embriões antes de congelá-los. Geralmente, apenas um embrião é transferido de cada vez para o útero para maximizar as chances de implantação bem-sucedida e uma gravidez.
“Mas e se não pudermos congelá-los?”, perguntou Collura. “Vamos responsabilizar criminalmente as pessoas porque você não pode congelar uma ‘pessoa’? Isso levanta tantas perguntas.”
Cientistas da medicina reprodutiva também criticaram a decisão, dizendo que foi uma “decisão médica e cientificamente infundada”.
“O tribunal decidiu que um óvulo fecundado congelado em um freezer de uma clínica de fertilidade deve ser tratado como equivalente legal a uma criança existente ou a um feto gestando em um útero”, disse Paula Amato, presidente da Sociedade Americana de Medicina Reprodutiva. “A ciência e o bom senso cotidiano nos dizem que não são.”
Mesmo no mundo natural, acrescentou, vários óvulos muitas vezes são fertilizados antes que um se implante com sucesso no útero e resulte em gravidez.
Amato previu que jovens médicos deixariam de ir para o Alabama para treinar ou praticar medicina após a decisão, e que médicos fechariam clínicas de fertilidade no estado se operá-las significasse correr o risco de serem processados civil ou criminalmente.
“O cuidado moderno com a fertilidade estará indisponível para o povo do Alabama”, previu.
Casais no meio de tratamentos de infertilidade exaustivos e custosos no Alabama disseram estar sobrecarregados com perguntas e preocupações, e alguns disseram temer que seus provedores sejam forçados a fechar suas clínicas.
Megan Legerski, de 37 anos, que atualmente está passando por tratamento de infertilidade, disse que recentemente engravidou depois de ser implantada com um embrião criado por fertilização in vitro, mas que sofreu um aborto espontâneo após oito semanas. Ela e seu parceiro têm mais três embriões congelados que podem implantar, disse ela.
“Os embriões para mim são nossa melhor chance de ter filhos, e estamos extremamente esperançosos”, disse Legerski. “Mas ter três embriões no freezer não é a mesma coisa para mim do que ter um que se implante e se torne uma gravidez, e não é a mesma coisa que ter uma criança. Nós temos três embriões. Não temos três filhos.”